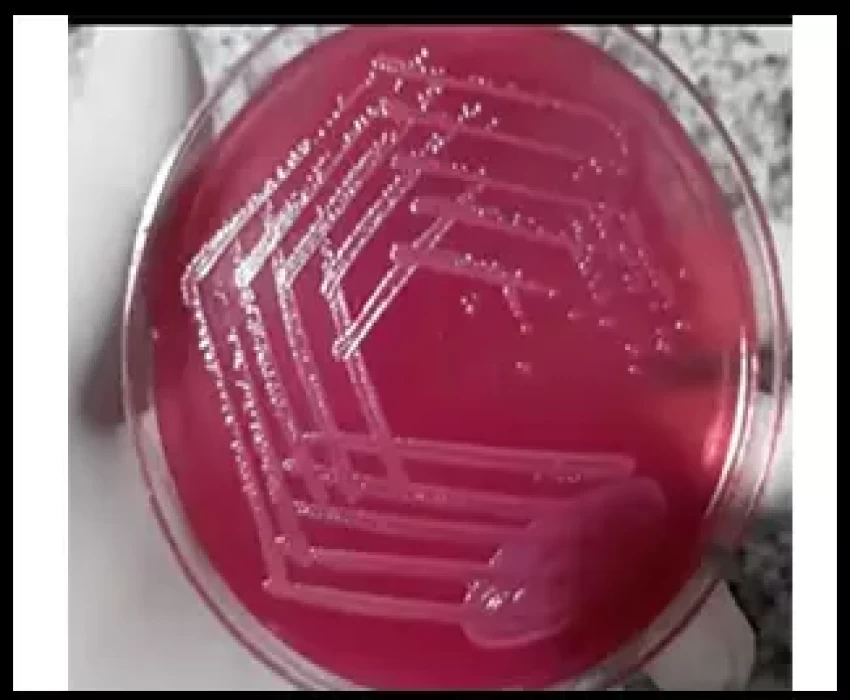
saraswati dental college

Introduction: Diarrhoea accounts for 1.6-2.5 million deaths annually in children in the developing world who experienced an average of 3 episodes of diarrhoea in a year. β- Lactamases continue to be the leading cause of resistance to β-lactam antibiotics among gram-negative bacteria. In recent years there has been an increased incidence and prevalence of extended-spectrum β-lactamases (ESBLs), enzymes that hydrolyse and cause resistance to oxyimino-cephalosporins, and aztreonam.
Materials and Methods: The study was done in MGM Medical College & Hospital, Kamothe, Navi Mumbai. The study period ranges from Feb 2012 to Jan 2013. A total number of 3148 clinical samples were analyzed and 100 isolates were taken in the study which was positive for E.coli infection. Antimicrobial susceptibility testing was determined to commonly used antibiotics using the modified Kirby-Bauer’s disc diffusion method and ESBL determination was done by the screening test and confirmatory test.
Results: The prevalence of ESBL E.coli was 49%. Out of 49%, the highest rate of Escherichia coli was isolated from pus samples 80%, which was followed by urine 60%. In order to prevent the outbreaks of this life-threatening infection caused by ESBL producers, certain infection control measures have to be followed.
Conclusion: The isolates of E.coli were highly resistant to all routine antibiotics with third-generation cephalosporins in the hospitalized patients as compared to non-hospitalized patients. Since ESBL production is more common among nosocomial pathogens, early detection will definitely help in controlling hospital infections that are caused by this group of organisms.